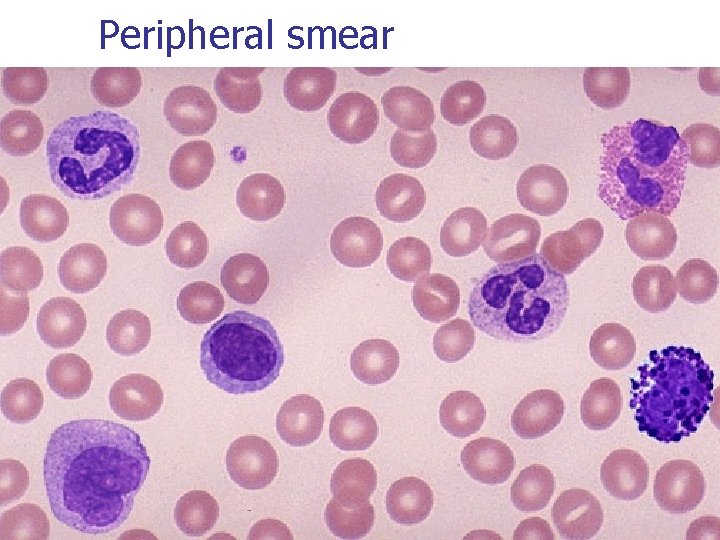
Peripheral smear

Special stains in Histopathology Special stains i Van

- Slides: 52
Special stains in Histopathology
Special stains i) Van Gieson’s stain ii) Masson’s trichrome stain iii) Papanicolou stain iv) Periodic Acid-Schiff stain v) Haematoxylin And Eosin stain vi) Toluidine blue stain
Collagen n n Acellular product of fibroblasts Singly/bundles Exists in several different forms Collagen type I, III – Interstitial n n n Type I skin, bone, tendon, blood vessels Type II hyaline cartilage & cornea Type III in association with type I Type IV Basement membrane collagen Type V specialized sites like placenta, atherosclerotic plaque
Trichrome stains n n n Selectively demonstrates collagen, muscle, fibrin and erythocytes. Differentiate colours tissue elements into three Contain three dyes, one of which is a nuclear stain
Factors affecting trichrome staining: i) Tissue permeability : Tissue + fixative agent n Insoluble protein network There are different types of protein network e. g. RBCs very dense network very small pores Muscle larger pores Collagen least dense network quite porous
Structure and density of protein network relates directly to the staining reaction of tissue component Eg: Smaller molecule dye RBCs Collagen Muscle Medium molecule dye Collagen Muscle Large molecule dye Collagen
ii. Molecular size of dye : Principle for trichrome staining – smaller dye molecule will penetrate and stain tissue elements, but if a larger dye molecule can penetrate the same element, the smaller molecule will be replaced by it. eg: Van Gieson stain: Picric acid 229 Acid fuchsin 586 Differential staining of collagen (more permeable) and muscle (less permeable) by simultaneous exposure to Van Gieson stain. n
Picric acid (smaller molecular weight) Stain (yellow colour) Collagen Muscle Acid fuchsin (larger molecular weight) Picric acid will As it is less porous be replaced acid fuchsin won’t be by Acid fuchsin able to penetrate it Red colour of Acid fuchsin Retain yellow colour of Picric acid
Other factors: - Heat increases the rate of staining increases penetration by larger dye molecule - p. H low p. H (1. 5 -3) is required for adequate and even staining of connective tissue fibres.
Van Gieson’s Stain n Components : saturated picric acid solution and 1%aqueous acid fuchsin solution in distilled water Uses : to stain collagen Color : collagen-red cytoplasm-parrot green nuclei-blue/black other connective tissue-yellow
Reagent : Aqueous picric acid 100 ml 1% Acid fuchsin 10 ml Method: Dewax and bring sections to water Stain with celestine blue haematoxylin (5 -10 mins) or by Weigert’s haematoxylin (20 -30 mins) Wash with tap water (15 -30 sec)
Differentiate with 1% acid alcohol (5 -10 sec) Wash with tap water Counterstain with Van Gieson’s (3 -5 mins) Rinse with 95% alcohol (DO NOT USE WATER) Dehydrate with absolute alcohol Clear in xylene and mount
Results : Cell nuclei blue / black Collagen bright red Muscle fibres yellow RBCs yellow Uses : i) Extent of fibrosis ii) Identifying collagenous tissue iii) As a counter stain Von Kossa for calcium
Precautions : i) Fixative : formaldehyde not good Zenker’s solution Bouins fixative ii) Degreasing : - trichloroethylene - 24 to 48 hrs - immediately after dewaxing iii) Washing in water after Van Gieson’s stain should be avoided
iv) Prefer Weigert’s haematoxylin over alum haematoxylin to avoid over differentiation. v) Nuclear stain should be intense as picric acid acts as differentiator. vi) Young collagen fibres do not get stained by Van Gieson vii) Other dyes : Methylene blue Aniline blue Amilo black
MASSON’S TRICHROME STAIN n n n Components : phosphotungstic acid, methyl blue, acid fuschin in glacial acetic acid and distilled water Uses : to stain collagen fibres and muscle tissue Color : collagen-blue/green cytoplasm, muscles, RBCs-red nuclei-blue/black
Reagents: Solution A : Acid fuchsin 0. 5 g Glacial acetic acid 0. 5 ml Distilled water 100 ml Solution B : Phosphomolybdic acid 1 g Distilled water Solution C : Methyl blue 100 ml 2 g Glacial acetic acid 2. 5 ml Distilled water 100 ml.
Method Dewax and bring section to water Celestin blue hematoxylin method Decolorize with 1% acid alcohol (10 -20 sec) Wash in tap water Acid fushsin solution (5 mins) Wash in distilled water
Treat with solution B (5 mins) Drain the slide Stain with methyl blue solution (5 mins) Rinse in distilled water Dehydrate with absolute alcohol Clear in xylene and mount
Acid fuchsin 586 Methyl blue 800 Acid fuchsin RBCs Muscle Collagen Methyl blue Collagen Results : Nuclei blue / black Collagen blue (methyl blue) Muscle & RBCs Red (acid fuchsin)
Hematoxylin and Eosin stain n Components : haematoxylin and eosin Uses : routinely used for epithelium and connective tissue Color : cytoplasm-light pink collagen fibres, muscle-pink nuclei-purplish blue RBCs-orange or red
q Hematoxylin: • Extracted from the logwood of the tree Haematoxylon campechianum. • • Hematoxylin itself is not a stain. The major oxidization product is hematein, a natural dye that is responsible for the color properties.
q 1. • • • Hematein can be produced from hematoxylin in two ways: Natural oxidation (‘ripening’) by exposure to light and air. This is a slow process, takes as long as 3 -4 months. Solution retains its staining ability for a long time. E. g. Ehrlich’s and Delafield’s solutions.
2. Chemical oxidation : Oxidation occurs instantaneously. n These solutions have a shorter shelf life. n Oxidation using sodium iodate e. g. Mayer’s hematoxylin. n Oxidation by mercuric oxide e. g. Harris’s hematoxylin
q q q • • • Hematein is anionic, having a poor affinity for tissue, and is inadequate as a nuclear stain without the presence of a mordant. Mordant is a substance which acts as an intermediary between dye and tissue. Classification of hematoxylin solutions according to the mordant used: Alum hematoxylins Iron hematoxylins Tungsten hematoxylins Molybdenum hematoxylins Lead hematoxylins
q • • • Alum hematoxylins : The mordant is aluminium, usually in the form of aluminium potassium sulfate and aluminium ammonium sulfate. Types and staining times: Cole’s Delafield’s Ehrlich’s Mayer’s Harris’s Carrazzi’s(progressive) Carrazi’s(regressive) Carrazi’s(frozen sections) Gill’s 1 (regressive) 20 -45 min 15 -20 min 20 -45 min 10 -20 min 5 -15 min 1 -2 min 45 sec 1 min 5 -15 min
q • • Disadvantage of alum hematoxylins: Sensitivity to any subsequently applied acidic staining solutions. e. g picric acid-acid fuchsin mixture in van gieson’s stain removes most of the hematoxylin so that the nuclei are barely discernible. A suitable alternative is the combination of the celestine blue staining solution with an alum hematoxylin which is resistant to the effects of acid.
IRON HEMATOXYLINS q q • • In these, iron salts are used both as the oxidizing agent and as mordant. Types: Weigert’s hematoxylin Heidenhain’s hematoxylin Loyez hematoxylin Verhoeff’s hematoxylin
The uses of hematoxylin stains i. ii. Alum : Nuclear stain used with eosin Iron : weigert – Nuclear stain used with acid dyes Heidenhain –Intranuclear detail, muscle striations Verhoff – Elastic fibers Loyez - Myelin iii. iv. Tungsten : Fibrin , muscle striations , glial fibers Molybdenum: Collagen , endocrine cell granules
n Principle: Hematoxylin, being a basic dye, has an affinity for nucleic acids of the cell nucleus.
EOSIN n n n i. iii. n n The eosins are xanthene dyes. Principle: Eosin is an acidic dye with an affinity for cytoplasmic components of the cell. Types: Eosin Y Ethyl eosin Eosin B Eosin Y is the most widely used. It is the most suitable stain to combine with an hematoxylin.
Standard H&E stain for paraffin sections q 1. 2. 3. 4. 5. 6. Method: Dewax sections, hydrate through graded alcohols to water. ? ? ? ? Remove fixation pigments if necessary. Stain in an alum hematoxylin of choice for a suitable time. Wash well in running tap water until sections ‘blue’ for 5 minutes or less. Differentiate in 1% acid alcohol for 5 -10 sec. Wash well in tap water until sections are again ‘blue’or
7. 8. 9. 10. Blue by dipping in an alkaline solution, followed by a 5 -min tap water wash. Stain in 1% eosin Y for 10 min. Wash in running tap water for 1 -5 min. ? ? ? Dehydrate through alcohols, clear and mount.
q • • • Results: Nuclei - blue/black Cytoplasm - varying shades of pink Muscle fibers – deep pink/red Red blood cells – orange/red Fibrin - deep pink
Papanicolaou stain n Components: Harri’s hematoxylin orange G 6 EA 50 Uses : to stain keratinised and non keratinised epithelial cells Mainly in exfoliative cytology Color : nuclei: blue/black cytoplasm: non keratinised epithelial cells-blue/gray keratinised epithelial cellsorange/pink
n n n pap stain is a multichromatic staining histological technique developed by George Papanikolaou, the father of cytopathology. Pap staining is used to differentiate cells in smear preparations of various bodily secretions; the specimens can be gynecological smears (Pap smears), sputum, brushings, washings, urine, cerebrospinal fluid, abdominal fluid, pleural fluid, synovial fluid, seminal fluid, fine needle aspiration material, tumor touch samples, or other materials containing cells. very reliable technique. it is used for cervical cancer screening in gynecology. The entire procedure is known as Pap smear.
n n The classic form of Pap stain involves five dyes in three solutions: A nuclear stain, haematoxylin, is used to stain cell nuclei. The unmordanted haematein may be responsible for the yellow color imparted to glycogen. First OG-6 counterstain (-6 denotes the used concentration of phosphotungstic acid; other variants are OG-5 and OG-8). Orange G is used. It stains keratin. Its original role was to stain the small cells of keratinizing squamous cell carcinoma present in sputum. Second EA (Eosin Azure) counterstain, comprising of three dyes; the number denotes the proportion of the dyes, eg. EA-36, EA-50, EA-65. n n n Eosin Y stains the superficial epithelial squamous cells, nucleoli, cilia, and red blood cells. Light Green SF yellowish stains the cytoplasm of all other cells. This dye is now quite expensive and difficult to obtain, therefore some manufacturers are switching to Fast Green FCF, however it produces visually different results and is not considered satisfactory by some. Bismarck brown Y stains nothing and in contemporary formulations it is often omitted.
Periodic Acid Schiff stain n Components : periodic acid and schiff’s reagent Uses : stains carbohydrates Color : carbohydrates-magenta fungal hyphae-magenta cytoplasm- pale blue nuclei-blue basement membrane-magenta
Toluidine Blue Stain for Mast Cells n n n Components : 1% toluidine blue in 50% isopropanolol Uses : amyloids and mast cell granules gives metachromasia for vital staining Color : mast cell granules-magenta pink background-blue
PLASMA CELL Size : 9 -20µ Nucleus Eccentrically placed with a wheel-spoke pattern Color : Dark purple Shape : ovoid Nucleoli : none Cytoplasm Abundant Color : Deep blue with a clear area next to the nucleus
MACROPHAGES Size : 15 -80 µ Nucleus Shape : Egg shaped or elongated N/C ratio : 2: 1 -1: 1 Color : Purple Chromatin : Spongy Nucleoli : None Cytoplasm Color : Sky blue Contents : Coarse azure granules, vacuoles, many neutral red bodies.
Melanosomes
Fibroblasts
Peripheral smear
References : 1. Theory and Practice of Histological Techniques by Bancroft, 5 th edition, pgs 139 -162. 2. Cellular pathology techniques by Culling 4 th edition, pgs 164 – 180. 3. Histological techniques and special stains note book, KLES Histopathology department, pgs 3 -8.